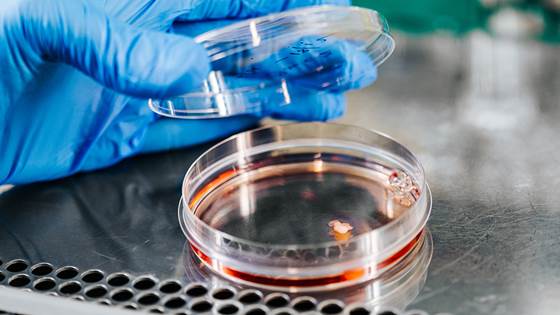

Transforming industrial CO2 waste into valuable feedstock
A EU-funded project will promote CO2 capture and improve economic sustainability by converting waste CO2 to value added products.

A EU-funded project will promote CO2 capture and improve economic sustainability by converting waste CO2 to value added products.

Ensuring material integrity throughout the hydrogen value chain - from production to transport, storage, and end use - is crucial for safe and efficient use of both hydrogen and ammonia.

Would you pay 1% more for a magazine if it could reduce the CO2 emissions associated with its production by 80%?

A new EU funded project aims to efficiently produce hydrogen from waste, ensuring strong energy performance with a fully carbon-negative approach.

The following is a short story about how stupid questions can change the course of an entire industry. And about how ingenious ideas can encounter opposition because they appear too good to be true.

Detecting small holes in cage nets in real time is not a technology that is readily available in today's market. The inspection company Njord Aqua and SINTEF have developed software that does just this and can thereby help reduce the risk of escapes...
Many great discoveries and inventions spring from basic research. That’s particularly true for medicine, but also for many other research areas.

It is essential that Norwegian towns and cities become climate-neutral. But how do we get this done? On the site of the old Oslo airport at Fornebu, researchers are demonstrating how real transformation can be implemented in practice.

SINTEF showcases our latest hydrogen achievements at EU Hydrogen Week 2024.

Say hello to the robot called Bifrost. With the help of AI technology, it uses its tactile capabilities to manipulate soft and pliable objects to order. Bifrost is in fact a world-beater.

Catching lice before they settle on the fish can improve fish welfare and reduce treatment-induced mortality. Now SINTEF Ocean lead a project where they investigate to what extent this is possible.

After eight years of pioneering research, the Norwegian CCS Research Centre (NCCS) held its closing conference on 13 and 14 November in Trondheim.

We throw away huge amounts of food. But would you change your behaviour if you knew the nutritional value of the food you waste?

Mona Mølnvik was awarded the OG21 Technology Champion 2024 prize.

A cure for global warming: Technologies exist that can get us out of this mess. Let’s take a look at them.

The SINTEF-sponsored EERA DeepWind offshore wind energy R&I conference has just announced that papers related to its most recent edition have been published.

SINTEF Ocean and the Global Centre for Maritime Decarbonisation (GCMD) have signed agreements for joint efforts in greening the maritime sector. This partnership will strengthen maritime decarbonisation

A recent innovation has the potential to accelerate the introduction of essential carbon capture processes in a range of industries. The technology has recently been demonstrated at a waste combustion plant in Bergen, with excellent results.

Have you been bitten by the running bug? If so, perhaps you’ve been asking yourself this very question. Well, we have the answer!

Data collection has now started at two Norwegian rivers to find out how to improve both power generation and environmental conditions

A new earplug can now serve as hearing protection, a music player, and a microphone – all at once! At the heart of this technology is a MEMS chip developed at SINTEF in collaboration with Minuendo.

Mona Mølnvik, Research Director at SINTEF, received the prestigious Green Award at the GHGT Conference in Canada.

(Joint press release) Imec expands Europractice portfolio by offering access to thin-film piezoelectric microelectromechanical systems (piezoMEMS) fabrication services from SINTEF, a leading European independent research institute in Norway.

The Norwegian Public Roads Administration (NPRA) has commissioned a team of SINTEF researchers to measure the respective health impacts of walking, cycling and the use of e-scooters to get to work.

For the past three years, MaritimeNH3 has investigated the potential of ammonia to be a safe, clean and cost-efficient alternative to fossil fuels in the maritime industry.

SINTEF Energy Research is pleased to announce that Gard Hopsdal Hansen will be taking over as the new Director of the FME NorthWind Research Centre.

An EU-funded project will improve data centres´ energy efficiency and sustainability by transforming energy management with innovative “immersion cooling” technology.

Exploiting more of the ocean's food potential requires new knowledge and technology. But where and when does it pay to fish for new species such as Calanus? This is when large data sets are needed.

Research indicates that workplaces which encourage a healthy integration between their employees’ work and personal lives have a happier and better performing workforce.

Many people can manage very well by using their cars less. But for this to happen, housing developments must be planned to make it easier. Astrid Bjørgen has been studying how this can be achieved.

Just two seconds of distraction from the traffic doubles the chances of an accident. Screen-based navigation is the cause of most concern.

Out of sight, out of mind? Far from it! Urine, faeces and toilet paper are the only things you should ever flush down the toilet. Anything else has a negative impact on marine life.

Data from our open ship design and test platform SINTEF Ocean Bulk Carrier (SOBC-1) can now be downloaded for use in research projects and case studies in for example green shipping.

It looks as though they might be. According to SINTEF, many of them exhibit properties that are at least as good as new timber. This is good news for materials reuse.

Mineral recovery by mining generates large volumes of surplus crushed rock that end up polluting natural environments. If we succeed in generating new knowledge, such surpluses can instead be used to manufacture concrete or improve agricultural soils...

Policies that feature nature-based solutions and strong collaborations are helping to close the gaps on climate resilience. Learn more in a new podcast.

Only one in three Norwegian municipalities monitors accessibility in its schools. The Norwegian Association for the Disabled is demanding urgent action.

If only techno-optimists get to test AI tools, the results simply aren’t good enough. This is where Tesla made a big mistake – a lesson that the health sector will do well to learn.

As electric vehicles (EVs) and renewable energy sources become more popular, the demand for high-performance batteries is skyrocketing. We need both more and better batteries to meet this demand.

After three years of waiting it has finally happened. Researchers have succeeded in getting a red sea cucumber, widely regarded as the world’s most expensive seafood, to spawn in the lab.

Shortfalls in crew numbers in the Norwegian ferry system are resulting in numerous cancelled crossings. Onshore control centres and new safety technologies are just some of the initiatives that may enable operations with smaller crews.

Everyone gets seasick, says researcher Toralf Sundin Hamstad at SINTEF, but there are tricks we can employ to avoid the worst of it.

No one likes sitting in a traffic jam. Research shows that the average Norwegian motorist is willing to fork out almost 100 kroner in order to spend one hour less in traffic. But traffic congestion can also be mitigated.

How can nature-based solutions help us harness the power of nature to adapt to and mitigate the impacts of climate change in cold regions? This is the topic of a new podcast.

Two new laboratories will test energy systems that will make shipping green, and constructions that are necessary for offshore wind and other energy development offshore.

The warning couldn’t be clearer. Standard plastic grocery bags are useful when we’re out shopping, but don’t use them to store food. So says research scientist Lisbet Sørensen at SINTEF.

Researcher Hanne Haslene-Hox at SINTEF claims that bacteria are much better than their reputation suggests. Each of us hosts as many as 38 million of them in our bodies.

He’s been called the father of carbon capture and storage in Norway – but Erik Lindeberg isn’t resting on his laurels. At 76, he’s still crusading to make sure this technology is put to use as quickly and comprehensively as possible, to help the...

The European Investment Fund (EIF) is intensifying its support for Norwegian technology startups by making its third and largest investment to date in SINTEF’s seed fund.

Milestone hydrogen news arrives from Cologne, as Shell has taken a final investment decision on REFHYNE II, a 100-megawatt renewable proton-exchange membrane (PEM) hydrogen electrolyser at the Shell Energy and Chemicals Park Rheinland in Germany.

Much of the plastic in the sea in Norway comes from the fishing industry. At least when we look at weight. Ropes. Nets. Buoys. Styrofoam. Clothes.

SINTEF contributed with research on bioprocess optimization in a project for establishing industrial microbiological fertilizers in Lithuania.

SINTEF has played a key role in the development of an innovative approach for testing wave energy converter (WEC) reliability, performance and destructivity.

For AI to help us solve the world’s major challenges, we need to invest in other types of machine learning, not only language models like ChatGPT.

Large amounts of digital data are needed to use artificial intelligence in materials research. The international standard, OPTIMADE, allows researchers to easily communicate with all relevant databases.

19 June 2024 – Over the past two days, 132 hydrogen researchers and industry professionals gathered in Trondheim, Norway for the first ever H2science conference.

By improving the reporting of catch volumes and fish health in European fisheries, the EU project OptiFish aims to contribute to more sustainable fishing and make it easier to meet current and future regulatory requirements.

For the most part, Norwegian girls enjoy going to school, whereas boys exhibit a marked dislike of the school setting. One of the problems is that boys experience school as unfair.

Higher expectations for CO2 capture and storage require more research on safe and cost-effective large-scale storage methods. At the Svelvik CO2 Field Lab, industry and researchers can test technology for monitoring CO2 storage in wells.

More green roofs and facades will help to create more space for natural habitats in our urban environments. A new set of guidelines has been prepared for those of us looking to green our roofs.

Is it possible to build greenhouses on the moon without transporting any materials from Earth? Researchers at NTNU Social Research and SINTEF believe it is, and are assisting the European Space Agency (ESA).

Protective shoes are stiff and heavy and made primarily for protection. Many people feel they’re more trouble than they’re worth. But research is coming to the rescue, with better ergonomics and a reduced climate footprint.

As early as next year, a hundred new hydrogen trucks will be rolling Norwegian roads – with zero emissions and a range of 500 kilometres. And that’s not all! It takes less than fifteen minutes to fill their tanks.

On 12 April, approximately 43 members of the European wave energy community, and associated industries, gathered in Perugia for IMPACT’s second workshop, organised by project partners SINTEF Energy Research and VGA.

Artificial Intelligence (AI) is well suited to observe and understand what is going on around a ship. However, before we can allow AI to make safety-critical decisions, we need to be aware of how certain the decisions are, as well as why AI makes...

By imitating nature, it may be possible to recover seabed minerals by extracting hot water from the Earth’s crust. We can harvest green energy and be sensitive to the environment – all at the same time.

Both the glass and aluminium industries cast glass in furnaces that generate large volumes of greenhouse gases. Researchers believe that replacing natural gas with hydrogen will enable us to remove greenhouse gas emissions and promote smarter...

Students, researchers and the building industry are collaborating to adapt our homes to climate change. And they’re identifying solutions that hadn’t been obvious before.

European industry is pivotal to current economic and societal shifts. To sustain prosperity, industrial ecosystems must innovate and adapt their products and services.

More than a million tonnes of fish residues can rescue the food and cosmetic industries from raw materials shortages – and create new jobs. The key factors here are oils rich in omega-3, collagen and gelatin.

In a world where both traditional security and climate play an increasing role, international cooperation has become particularly important. On Tuesday 16. April, the commanders of seven of the Arctic nations’ coast guards met for the Artic Coast...

By replacing natural gas with hydrogen and safer and smarter production methods, an EU-funded project will decarbonise the glass and aluminum industry.

A recent report from SINTEF reveals that children and young people in the welfare system attend more out-patient mental health service appointments than other children. However, both they and their parents think that the help they are getting is...

Reducing energy consumption and replacing fossil with renewable fuels within the maritime sector is a large and global challenge. The new Norway-based research center FME MarTrans aims to find sustainable solutions for the maritime energy transition.

– On 11 April, the Research Council of Norway announced an investment of 180 MNOK in a new research centre on carbon capture, transport and storage (CCS) in Norway.

Norwegian politicians should not be sponsoring the race to expand the use of AI. The process is wasting too much energy.

Norway's Minister of Energy, Terje Aasland, announced the creation of a new research centre that will look at ways to reduce the energy transition's monetary cost and impact on nature.

Researchers have recently found out how to use algae to convert ammonia and nitrates into a nutrient-rich fertiliser or fish feed ingredients.

Conventional breeding techniques result in major and uncontrolled modifications to the genetic material of plants and animals. If arguments based on the ‘precautionary principle’ are used as blindly on this issue as in the gene technology debate...

By converting by-products from the sawmill industry into proteins for fish feed, both the forestry and fish feed industries can achieve a more environmentally friendly and high-quality product

Researchers are testing and protecting old brickwork as their contribution to the renovation of the heritage building Sophies Minde in Oslo. Results indicate that much of this material can be reused.

Women’s bodies and their health in general have for too long been assigned low priority in the field of research. But an innovative and extraordinary technology may now offer us new treatments for conditions such as endometriosis.

The towing tank at Tyholt, Trondheim, is re-opening this spring after the installation of a brand-new wave maker.

Friday 1 March another Norwegian fisherman was drowned while working. He became the 156th Norwegian working in the industry to lose his life since the new millennium. A safety researcher at SINTEF says that this only goes to underline the message...

Norway leads the world when it comes to the use of robots in the aquaculture sector. But how do these robots actually impact on the fish? Cyberneticist Eleni Kelasidi is surprised by just how much.

Investing in research, local manufacturing and secure access to materials is needed to solidify Norway’s position as a leader in sustainable batteries.

The new Google data centre being built in Skien is in danger of wasting its surplus heat because Norway has no legislation that reduces this risk. We really need to address this issue!

When you purchase a new refrigerator, tumble dryer, or air-to-air heat pump, you have a chance to positively impact the environment. Research conducted by SINTEF has shown that refrigerants are a crucial factor in the battle against global warming...

Rainfall patterns, runoff, and temperature conditions also change when the climate changes. This creates both new challenges and opportunities for Norwegian hydropower.

Does it matter if a small area of rare wetland is lost if a lot more of the same area remains intact? In Norway, it is impossible to say, because no-one can show how many such wetlands are being destroyed elsewhere at the same time.

Did you know that the chemical industry supplies products to virtually all other value chains, including the food, construction, health and transport sectors? All these industries are now having to renew themselves as part of the green transition...

If the Norwegian government rejects the majority opinion of the Gene Technology Committee, it will miss a long overdue opportunity to boost food safety, improve animal welfare and promote more eco-friendly pesticides.

Research scientists from 16 countries are joining forces to make a bulk carrier climate neutral – all with the help of a new power train.

Norway is world leading in the use of robotics in the fish farming industry. But how does the technical equipment affect the fish? Surprisingly much, says cyberneticist Eleni Kelasidi.

Power cuts can be caused by heavy snow and icing, as well as lightning strikes and strong winds bringing down power lines. Together with more extreme weather events, Norway is also facing a major power supply deficit. So, what can we do to avoid a...

If Europe is to meet its climate targets, offshore wind has to play a larger role in the energy mix. One thing is to produce all these wind turbines, another is how to attach or moor them. There is currently insufficient production capacity for...

Families who obtained help to purchase their homes improved their lives in many ways. But outcomes were not so positive for those renting as part of affordable housing allocation schemes.

Research is revealing that a cod-like fish called ‘cusk’ may soon be making a big splash on Norwegian dinner plates. But you will have to search long and hard to find it on sale today.

Results from a major study may contribute towards developing windows that can withstand harsher climatic conditions involving heavier rainfall and stronger winds. Because that’s exactly what we can expect in the future.

It is currently prohibited to provide animals with feed derived from the same animals’ own ‘value chain’. But this legislation is not based on science.

Well, some researchers believe this is possible. Species living at depths between 200 and 1000 metres may be very valuable. However, harvesting them isn’t as easy as it might sound because, when taken on board, valuable catches change rapidly from...

A new project which SINTEF is taking part in will look at better ways to deal with industrial wastewater.

SINTEF researchers are applying methodologies used to transport oil and gas in their efforts to upscale a technology for carbon capture and storage. This is good news for the climate.

One of Norway’s biggest achievements to date in the practical application of artificial intelligence is in identifying bone fractures. The secret of this success may be of benefit to many of our business leaders.

On 30 January 2024, the final GreenShift event was held in Brussels. The GreenShift project aims at fostering innovation and collaboration in the North Sea region.

The Norwegian government has decided to phase out the country’s Regional Research Funds. This is incomprehensible to those of us who have watched this initiative function successfully as a springboard for green innovation and transition in many small...

Solar storms are no joke. It may get cold and it may get very dark. Our mobile networks may be severely disrupted.

MISSION, a new EU-project, will develop and demonstrate three new SF6-free switchgear components.

Match load in international football is becoming so high that it is threatening the health of our players. So much so, that the product itself may also be under threat.

Necessary reductions in greenhouse gases will be achieved too late if we have to wait for all our aircraft, ships and trains to transition from fossil fuels. This is why we need biofuels – in spite of the criticisms levelled at their use in a recent...

In the sea, fish feed on species lower in the food chain. Can these same species form the basis of a new feed industry supplying the fish farming sector?

New lubricants, combined with new knowledge about how they should be applied to train wheels and rails, have the potential to reduce rail sector costs in Norway by hundreds of millions of kroner during the next decade.

A new seaweed farm have been established off the coast of Trøndelag. The project kicked off last year. This summer the cultivation license was granted and now the first seaweed seedlings have been deployed. The offshore facility will be used, among...

The electricity grid in Norway needs more balancing power. Neighbourhood communities can help by participating in a new market where intelligent consumer planning enables them to save money.

Farmed fish suffer if there is too little oxygen in the water. A system that can display oxygen concentrations may make it easier to supply this essential gas if the water becomes oxygen-poor.